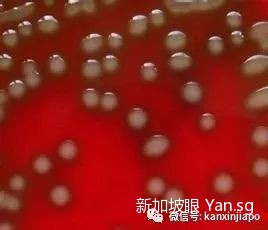

新加坡男孩被虫子咬了,住院42天,差点截肢
新加坡一个名叫Imraan Danish的男孩,被虫子叮咬后,伤口感染了A族链球菌(Group A Streptococcus),差点截肢。

▲图片来自Imraan Danish母亲的facebook
男孩的妈妈透露,孩子右腿不知道被什么虫子咬了,一开始没注意到,孩子觉得痒就用手去抓,可能是手上或伤口周围有A族链球菌,因此感染了。
A族链球菌是食肉菌的一种,主要通过伤口或发炎的咽喉进入人体。在人体内的繁殖能力很强,可在短时间内致人中毒性休克甚至死亡。——来自百度百科
孩子出现不适后,病情迅速加重,送医后住院一个多月,其中两个星期住在重症加护病房,动了几次手术才脱离危险。因为右腿是源头,医生一度考虑截肢。
1月24日,男孩的妈妈发facebook,儿子在住院42天后,终于出院了。但是还是要继续吃药,每周复诊两次,腿上的伤口也有所好转,但仍有可能需要截肢。

▲facebook截图
新加坡的虫子是出了名的毒,相信很多都被咬过,还获得了“纪念章”。
有网友被一只蚊子咬成了这样:

还有网友被不明生物搞成了这样:

真是说多了都是泪啊~
虽然这个案例里,并不是虫子直接导致细菌感染,但大家还是要提高警惕,不要随意触碰蚊虫叮咬后的伤口,出现不适及时就医。
评论